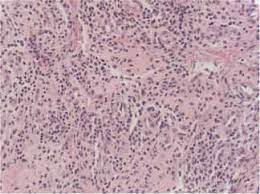
¿Qué es la Agranulocitosis?

La agranulocitosis, una condición hematológica distintiva, se caracteriza por la presencia de neutropenia severa y la supresión de la granulocitopoyesis, proceso fundamental para la formación de células granulocíticas, especialmente los neutrófilos. Estos últimos son esenciales en la respuesta inmunitaria, desempeñando un papel crucial en la defensa del organismo contra infecciones bacterianas.
¿Qué es la Agranulocitosis?
Esta afección, en muchos casos, se presenta como una reacción idiosincrásica a ciertos fármacos, indicando que la respuesta es atípica y específica de cada individuo frente a una sustancia particular. En este contexto, es altamente probable que esta reacción implique la supresión inmunitaria de las células progenitoras granulocitopoyéticas en la médula ósea. En otras palabras, el sistema inmunológico del paciente reacciona de manera anormal contra estas células, desencadenando una marcada disminución de los neutrófilos circulantes.
Un rasgo distintivo de la agranulocitosis es su propensión a atenuarse casi invariablemente al interrumpir el fármaco responsable. Al suspender la administración del medicamento desencadenante, se rompe el ciclo de la respuesta inmunitaria aberrante, permitiendo la recuperación progresiva de la producción de neutrófilos en la médula ósea. Este fenómeno destaca la importancia crucial de la identificación temprana y la acción inmediata al detectar esta reacción adversa a los medicamentos.
La agranulocitosis, en lugar de ser simplemente una respuesta a ciertos medicamentos, también se manifiesta en pacientes con enfermedades autoinmunitarias establecidas, como el lupus eritematoso sistémico, el síndrome de Sjögren y la artritis reumatoide. Este fenómeno añade una capa de complejidad a estas condiciones autoinmunitarias al presentar una neutropenia severa y la consecuente supresión de la granulocitopoyesis.
Las causas subyacentes de la agranulocitosis en estos casos son diversas. En algunos escenarios específicos, la presencia de anticuerpos mielodepresores emerge como factor desencadenante. Estos anticuerpos tienen la capacidad de inhibir la producción de células granulocíticas en la médula ósea, contribuyendo directamente a la neutropenia característica de estos pacientes. Por otro lado, en otras instancias, la agranulocitosis puede estar relacionada con la actividad de linfocitos T, los cuales ejercen una supresión directa sobre la granulocitopoyesis.
En el ámbito terapéutico, se destaca que el tratamiento inmunodepresor a menudo se revela como una opción eficaz. Este enfoque, diseñado para reducir la actividad del sistema inmunológico, desempeña un papel crucial en la gestión de la agranulocitosis, especialmente en aquellos casos graves que se asocian a infecciones recurrentes. La acción inmunodepresora ayuda a atenuar la respuesta inmunitaria anormal, permitiendo así la recuperación de la producción de células granulocíticas en la médula ósea.
En síntesis, la agranulocitosis no solo se manifiesta en respuesta a ciertos medicamentos, sino que también puede ser una manifestación intrínseca de enfermedades autoinmunitarias establecidas. Las causas subyacentes, ya sean anticuerpos mielodepresores o la actividad de linfocitos T, resaltan la diversidad de los mecanismos patofisiológicos involucrados. El tratamiento inmunodepresor emerge como una estrategia clave, especialmente en casos graves asociados a infecciones recurrentes, contribuyendo significativamente a la gestión clínica de esta compleja condición.